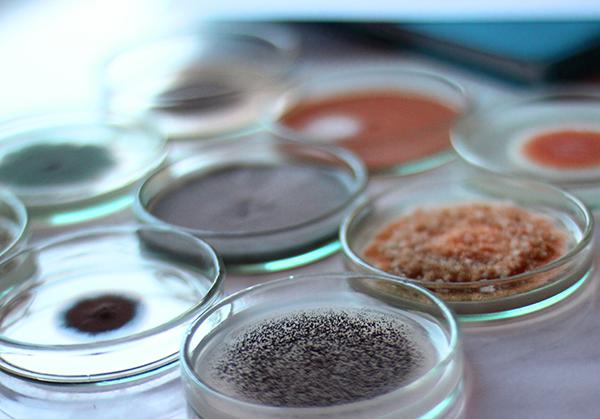

Laboratory quality assurance and quality control are used to document the quality of analytical data obtained through the soil sampling process.
Our data review process involves planning, assessing, reporting, and quality improvement tasks which are designed to establish the reliability of laboratory data. This process of evaluating the quality of analytical data to determine whether the data are of sufficient quality occurs over two-steps.
The first step is a data quality assessment to identify and summarize any quality control problems that occurred during laboratory analysis. These results are then used to perform a data usability evaluation to determine whether or not the quality of the analytical data is sufficient for the intended purpose.